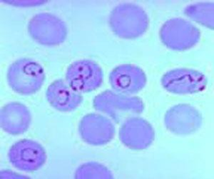
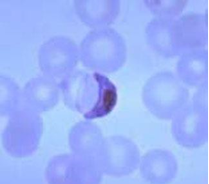

Acute pneumonia is associated with increased mortality in HIV-infected children, especially if they are not on antiretroviral therapy (ART) or if they have chronic lung disease, including bronchiectasis and lymphocytic interstitial pneumonitis.
HIV-infected children usually have a higher risk of pneumococcal infection than HIV-uninfected children. The incidence and hospitalization due to invasive pneumococcal disease (IPD) in HIV infected children decreases markedly by up to 80% when ART and pneumococcal conjugate vaccine are co-administered.
Lower CD4 counts, high viral load, and not being on ART increase the risk. Streptococcus pneumoniae (pneumococcus) is the most common cause in addition to staph aureus and gram negatives such as Haemophilus influenzae type b (Hib).
Diagnosis:Same as for HIV negative children
Treatment:β lactam antibiotics with gentamycin. Consider treating for pneumocystis pneumonia especially in very young children requiring oxygen therapy.
Both measles and HIV infection cause immunosuppression. The immunosuppression in measles is transient with depression of cellular immunity while HIV infection causes progressive immunodeficiency of both humoral and cellular immunity.
Severe complications and death may occur in children with HIV co-infection with mortality rates varying from 40 to 70%.
Case definition for measles: Fever with a generalized maculopapular rash and one of the following - Cough, coryza (runny nose) and conjunctivitis (red eyes). A history of contact with someone with the disease is useful.
A pathognomonic enanthema (Koplik spots) may be seen at the corner of the cheek at the prodromal phase. The rash is usually preceded by the fever, has a cephalocaudal distribution, appearing behind the ears and face and later spreading to the trunk and lower limbs. The rash is desquamating disappearing in the order of its appearance.
The diagnosis of measles is mainly clinical. For surveillance purposes, serological test to confirm the presence measles IgM in the blood is required.
The most common complication is pneumonia which requires antibiotics as >50% of all cases of pneumonia in measles have secondary bacterial infection (Staph aureus, Strep pneumonia, Haemophilus influenza and Klebsiella pneumonia).
Other complications are otitis media, diarrhoea, laringotracheobronchitis (croup), corneal and retinal damage from the infection or from instillation of harmful local remedies. Mouth ulcers, neurological complications –short term: convulsions, encephalitis and long term sub-acute sclerosing panencephalitis (SSPE) characterised by personality changes and gradual cognitive deterioration, are other important complications. Severe acute malnutrition may result as measles is a severely catabolic disease.
The WHO recommends that in areas where there is a high incidence of both HIV infection and measles, the first dose of a measles-containing vaccine is offered as early as age 6 months, with two additional doses of measles vaccine administered to the children.
Measles vaccine is not recommended when the CD4 percentage <15% at any age or CD4 count <200/mm3 for persons aged >5 years since several severe and fatal measles cases have been reported in severely immunosuppressed HIV-infected persons after measles vaccination.
Administration of immunoglobulin to HIV-infected children is advocated when measles exposure has occurred, irrespective of the immunization status.
Vitamin A is indicated - 50 000 IU (if aged < 6 months), 100 000 IU (6–11 months) or 200 000 IU (1–5 years). Early initiation of antiretroviral therapy is also essential.
Recovery after acute measles is often delayed for many weeks and even months, especially in children who are malnourished.
Syphilis is caused by the spirochete Treponema pallidum, a corkscrew-shaped bacterium. Syphilis in children is usually congenital or very rarely acquired through sexual abuse. Syphilis facilitates perinatal HIV transmission. HIV-infected women have a higher prevalence of untreated or inadequately treated syphilis during pregnancy, which places their new-born children at a higher risk of congenital syphilis. Congenital syphilis is generally acquired through transplacental transmission of spirochetes in the maternal bloodstream or, occasionally, through direct contact with an infectious lesion during birth.
Untreated early syphilis during pregnancy can lead to spontaneous abortion, stillbirth, hydrops fetalis, preterm delivery, and perinatal death in up to 40% of pregnancies. T. pallidum is not transferred in breast milk except if the mother has an infectious lesion (e.g., chancre) on the breast.
Presentation:Manifestations in congenital syphilis are defined as early if they appear in the first 2 years of life and late if they develop after age 2 years. About 60% of neonates with congenital syphilis are asymptomatic at birth. If untreated, asymptomatic infants can develop clinically apparent disease in the ensuing 3 weeks to 6 months.
Early congenital syphilis (≤2 years): Hepatosplenomegaly, jaundice, mucocutaneous lesions (e.g., skin rash, nasal discharge, mucous patches, condylomata lata), lymphadenopathy, pseudoparalysis of an extremity, haematological abnormalities (anaemia, thrombocytopenia), pneumonia, and skeletal lesions (e.g. osteochondritis, periostitis, or osteitis). Fever, nephrotic syndrome, ophthalmologic manifestations may also occur.
Late congenital syphilis (>2 years): Involvement of the central nervous system (neurosyphilis), bone (saber shins, saddle nose), teeth (notched, peg-shaped incisors (Hutchinson teeth), eyes (interstitial keratitis), sensory-neural hearing loss (eighth cranial nerve deafness).
Other congenital infections (toxoplasmosis, rubella, cytomegalovirus, herpes simplex virus, neonatal sepsis), and other causes of neonatal hepatitis, hydrops fetalis, long-bone abnormalities, and cutaneous scaly lesions.
Laboratory diagnosis:Definitive diagnosis is by dark field microscopy performed on body fluids (e.g., nasal discharge) or moist skin lesions demonstrating thin, delicate, corkscrew-shaped organisms with rigid, tightly wound spirals. Failure to identify spirochetes with dark field microscopy does not exclude the diagnosis of syphilis.
The infant is evaluated with non-treponemal reaginic tests (rapid plasma reagin (RPR) and the Venereal Disease Research Laboratory (VDRL) which are quantitative, and compared with the same test done at the same laboratory on the mother’s serum. The neonate’s non-treponemal titre usually is one to two dilutions less than that of the mother. A quantitative non-treponemal serologic titre in an infant that is 4-fold or (more) higher than the mother’s is suggestive of infection. A reactive nontreponemal test must be confirmed by a specific Treponema test such as fluorescent Treponema antibody absorption (FTA-ABS) or T pallidum particle agglutination (TPPA).
Further evaluation includes a complete blood count and differential and platelet count, long bone radiographs, and CSF analysis for VDRL, cell count, and protein. A positive CSF VDRL test, elevated CSF protein, and/or elevated CSF white blood cell (WBC) count without other causes may be due to congenital syphilis. Other tests should be performed as clinically indicated (e.g., chest radiograph, liver-function tests, cranial ultrasound, ophthalmologic examination, auditory brainstem response).
Treatment:Penicillin remains the treatment of choice for syphilis, congenital or acquired, regardless of HIV status.
Aqueous crystalline penicillin G 100,000 to 150,000 units/kg/day, administered as 50,000 units/kg/dose intravenously (IV) every 12 hours during the first 7 days of life and every 8 hours thereafter x 10 days.
If congenital syphilis is diagnosed after age 1 month, the dosage of aqueous penicillin G should be increased to 200,000 to 300,000 units/kg/day IV, administered as 50,000 units/kg/dose IV every 4 to 6 hours x 10 days.
If 1 day of therapy is missed, the entire course should be restarted. An alternative to aqueous penicillin G is procaine penicillin G 50,000 units/kg/dose IM in a single dose daily x 10 days. However, penicillin G is preferred because of its higher penetration into the CSF.
Acquired syphilis in children and adolescents is treated with a single dose of benzathine penicillin G 50,000 units/kg IM (up to the adult dose of 2.4 million units) for early-stage disease. For late latent disease, 3 doses of benzathine penicillin G 50, 000 units/kg (up to the adult dose of 2.4 million units) should be administered IM once weekly for 3 doses (total 150,000 units/kg, up to the adult total dose of 7.2 million units). Neurosyphilis should be treated with aqueous penicillin G 200,000 to 300,000 units/kg body weight per dose IV every 4 - 6 hours (maximum dosage: 18–24 million units/day) x 10 - 14 days.
A sustained 4-fold decrease in titre demonstrates adequate therapy. Treponemal tests usually remain positive for life, even with successful treatment.
Diarrhoea is more likely in children with HIV, and the leading cause of death among HIV-infected infants. Diarrhoea tends to be prolonged and usually complicated by dehydration and malnutrition.
It is classified into 3:
The usual infective causes of acute diarrhoea are also prevalent in HIV-infected children, the commonest of which is Rotavirus. Additionally, cryptosporidiosis, isosporiasis, CMV infection, atypical Mycobacteria species, and parasitic infections, including Strongyloides stercoralis and Tricuris tricuria may be implicated.
Malaria is caused by plasmodium parasite transmitted via the female anopheles mosquito. There are five plasmodium species - P. falciparum, P. vivax, P. ovale, P. malariae and P. knowlesi. P. falciparum causes the most serious form of the disease and is common in the tropics. Non-falciparum malarial infections are less common in sub-Saharan Africa. In endemic areas, with repeated infections, partial immunity is developed to the disease. Parasitaemia still develops but the severity of clinical symptoms may be less.
There is a geographic overlap in malaria and HIV. HIV increases the risk of malaria and reduces the acquired natural immunity to malaria as a result of the immunosuppression. More severe manifestations of P. falciparum malaria including severe acidosis, anaemia, respiratory distress and hyperparasitaemia and increased mortality were reported when compared with HIV-uninfected children. Bacteraemia is an important consideration especially with non-typhi salmonella (NTS) in HIV-infected children especially in those with severe malaria anaemia.
Uncomplicated malaria – The clinical signs and symptoms of malaria are non-specific and include fever, headache, malaise, chills, anorexia, vomiting and arthralgia. On physical examination, liver and spleen may be palpable.
Severe malaria – Severe malaria is defined by clinical or laboratory evidence of vital organ dysfunction. Many of the clinical manifestations result from parasitized (and non-parasitized) red blood cells adhering to small blood vessels causing small infarcts, capillary leakage, and organ dysfunction.
Features of severe malaria (shown in the boxes below) can occur singly or, more commonly, in combination in the same patient. High parasitaemia; parasite densities >100 000/μl (~2.5% parasitaemia) in low-transmission areas and more in endemic areas is a risk factor for death.
Microscopy (gold standard) – Thick and thin blood films to detect the malaria parasites.
Where microscopy is unavailable or not feasible, rapid diagnostic test (RDT) may be used. RDT detects HRP2 antigen in P. falciparum.
In more severe cases of malaria, additional tests would be required when available: Serum glucose, CSF analysis to rule out meningitis, full blood count (anaemia, thrombocytopaenia, polymorphonuclear leukocytosis may be present), serum electrolytes, urea and creatinine as well as blood culture to rule out bacteraemia.
Urinary tract infection, tonsillitis, viral illness, pneumonia, septicaemia, meningitis, enteric fever, yellow fever, dengue fever.
Due to widespread high-level resistance to chloroquine and sulfodoxine/pyrimethamine (SP), they are not to be used in the treatment of P. falciparum infections.
Uncomplicated malaria - The current treatment of choice for uncomplicated malaria is Artemisinin Based Combination Therapy (ACT) – Arthemeter/Lumefantrine or Arthemeter/Amodiaquine. ACT has minimal side effects and is effective against all stages of the parasite.
For P. vivax and P. ovale disease, primaquine treatment is added to clear the liver stages of the parasites to prevent relapse: 0.25–0.5 mg base/kg body weight in two divided daily doses should be given for 14 days.
| Weight | Number of tablets / dose |
|---|---|
| 5 - <15 kg | 1 tab twice daily x 3 days |
| 15 - <25 kg | 2 tabs twice daily x 3 days |
| 25 - <35 kg | 3 tabs twice daily x 3 days |
| > | 4 tabs twice daily x 3 days |
Severe malaria -IV artesunate given at 0, 12, 24 hours and then daily.
Revised dose recommendation for parenteral artesunate:
Children <20 kg: 3 mg/kg/dose
≥20 kg: 2.4 mg/kg/dose
Parenteral therapy must be given for a minimum of 24 hours. Follow on treatment once the patient can tolerate orally consists of a complete course of ACT.
Alternative treatment for severe malaria is IV Quinine starting with a loading dose of 20 mg/kg, then 10 mg/kg 8 hourly for 7 days. Toxicity of quinine includes nausea, vomiting, hypoglycaemia, tinnitus and cardiac arrhythmias.
Other supportive therapy to correct hypoglycaemia, treatment of seizures with anticonvulsants and ensuring adequate fluid balance is important. Therapeutic response needs to be monitored 12-hourly with parasite count.
Mosquito bite prevention
Chemoprophylaxis (for travellers)
Immunization: A child vaccine in addition to existing malaria interventions is desirable for an improved malaria control. The RTS S malaria vaccine candidate has been developed and is awaiting policy recommendations.